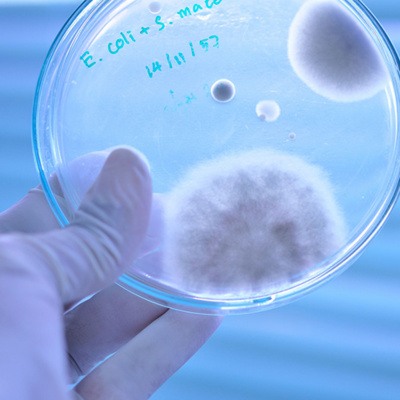

Mgfamiliar
(42) Prescrição racional de antibióticos
- Autor: Vários
- Narrador: Vários
- Editora: Podcast
- Duração: 0:09:11
- Mais informações
Informações:
Sinopse
Intervenções comportamentais diminuem a prescrição inadequada de antibióticos - Link Orientações clínicas elaboradas pelo American College of Physicians - Link